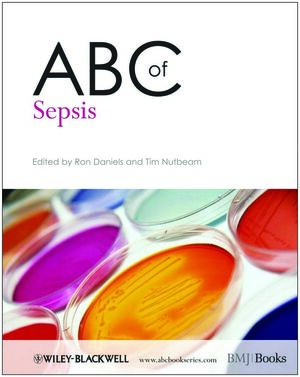

How To Get Rid Of Yeast Infections Once And For All
1. add to cart
→
Click "Add to Cart" below (shows €0.00 for subscribers)
2. confirm download
→
Review and confirm your selection in the cart
3. download
→
Get instant access to both EPUB and PDF formats
Related Books
Essential Oils To Boost Immunity And Fight Infections
🔒 Membership Required
Subscribe to unlock this eBook